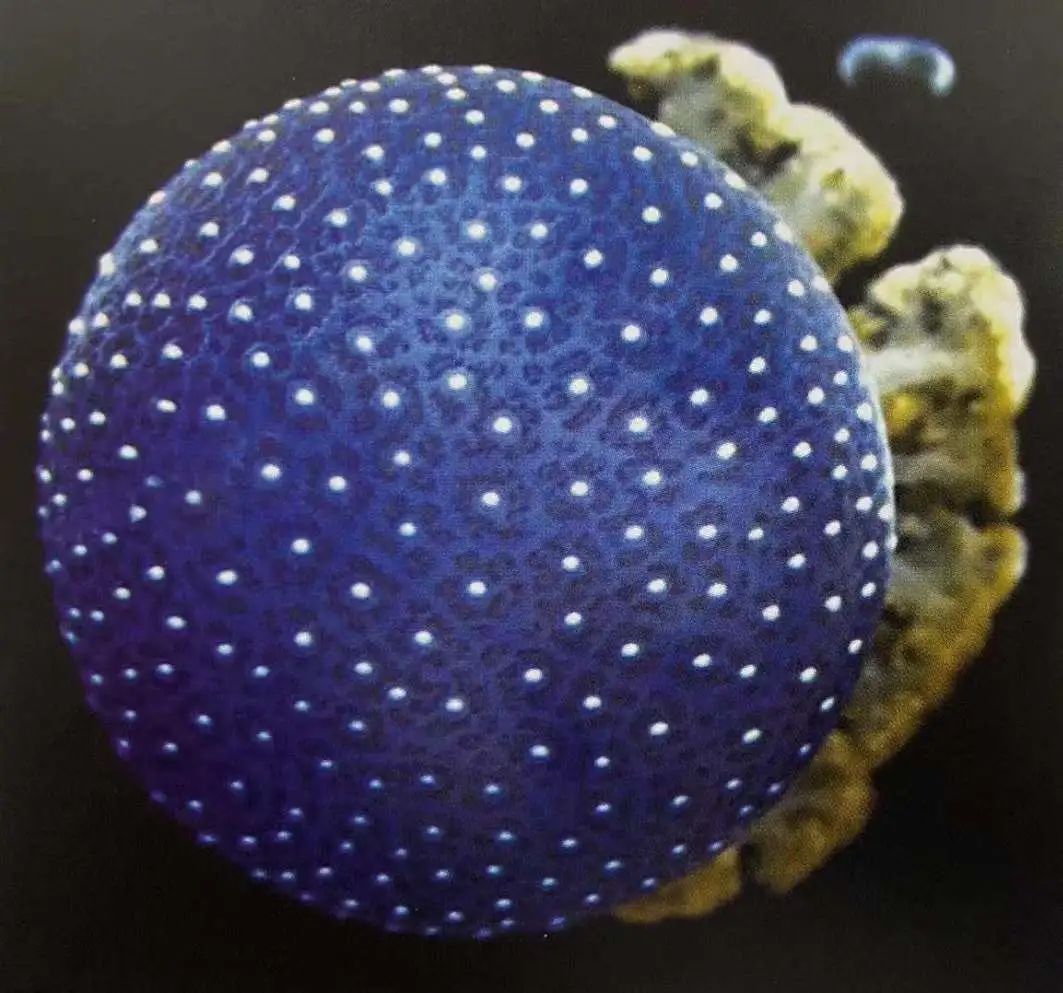

还没时间到杨浦区图书馆观看线下看展?那就跟着小编一起来解构面料的神奇世界吧!
服装创意面料设计是什么?
服装创意面料设计就是对服装材料的创新运用,其概念有两层意思:第一,从设计表现形式的角度讲,服装创意面料设计是设计师按照自己审美或设计的需要对服装材料进行的创新运用,赋予传统织物新的印象和内涵,提升面料的表现力,重塑面料的新形象;第二,从技术加工层面上说,服装创意面料设计是设计师在现有的面料或纤维材料基础上,对面料进行加工改造,即对面料进行轧褶、绗缝、缕空、机绣、贴布、勾针、编结等特殊工艺手法加工,使其产生前所未有的视觉效果和独特的艺术魅力。
服用面料是服装设计的三大基本要素之一,是服装存在的物质条件。在极力提倡“原创设计”概念的今天,服装的艺术设计要体现丰富的思想内涵,独创而具有艺术品质的面料是不可缺少的创作材料。


创意面料设计的灵感从何而来?
通过设计技法实验
激发设计灵感
设计师要对面料进行各种工艺实验,从中摸索各种面料和不同工艺结合后的效果。构思过程是以实验为起点,通过对某种材料,某种加工方法进行试验,工艺实验往往具有偶发性和随意性的特点,设计师要将各种方法和效果进行比较,重新组合或者延续一些比较满意的设计效果继续发展,最后在工艺实验的方法和各种灵感图片中找到设计的交叉点,实现设计的主题化和系列化。








这组创意面料作品所使用的工艺都是绗缝的方法。设计师在工艺实验后,认为第一幅面料的效果很有趣,联想到中式建筑的屋顶,于是着手收集各种建筑的造型,从中选出几款各国著名建筑的图片,通过绗缝工艺来表现这组建筑物的屋顶造型。
通过图片转化挖掘设计灵感
收集自己感兴趣的图片、实物等等,通过仔细观察分析,或者受到某些事物的外形、结构、色彩纹样或形式的启发,用多种材料和工艺结合实验,形成特殊的设计效果。有时,通过图片寻找的设计灵感而构思,甚至可以从一张图做出一系列的创意面料。
由图片寻找灵感,将传统的装饰纹样或自然形态进行转化设计。同一张图片作为灵感源,不同的设计师,利用不同的材质和技法,设计出完全不同的作品。
实例1



实例2


通过模仿自然界
获取设计灵感
创意面料主题与灵感的发掘与寻找需要具有一双发现美的眼睛,从自然界中发掘和积累素材。自然界的美数不胜数,如水波的荡漾、瑰丽的石头以及自然界宏观的天文奇景,地貌特质,微观世界中各种动植物的生态肌理等等,都是我们产生灵感的绝好题材。
1
模仿自然形态的设计

面料模仿泡沫在水中斑驳多重的光影效果。上下两层为皮革镂刻,中间用蓝色透明柯根纱间隔,形成多层重叠效果。

将一些贝壳珠子穿入纱线中,随着色彩的渐变效果,珠子散落在起伏的曲线中,如同退潮时海边沙滩的痕迹。
2
模仿海洋生物的设计

模仿微观状态下珊瑚虫在水中飘动的灵动效果。将白色雪纺纱和金色欧根纱裁成圆形,烧边后再用白色珠子钉缀在绿色面料上。

欧根纱卷边模仿寄生于珊瑚表面的海葵形态。
3
模仿植物形态的设计

模仿石榴的底部花瓣,用几层粉色无纺布裁开层叠翻折,再用红色绗缝线迹勾勒出石榴的造型。

表现放大的石榴籽的形态特征。
4
从微观角度着手设计

用线镶在上下三层化纤面料上,烙出大小不等的孔洞,蓝色表面上露出一点粉色点缀,再用深色线迹绣出环状的轮廓,模仿显微镜下细胞的水泡效果。

选择表面具有明显褶皱的面料作底,用特殊的胶质颜料在面料上绘出细胞的轮廓,再将黑色珠子和粉色透明纱片钉缀在黑色之间。胶质颜料干燥后会保持突起的触感并有光泽,与褶皱的底料形成肌理对比。
从历史、文化和日常生活中寻找灵感
从历史、文化和日常生活中寻找灵感也是着手设计的重要途径。这些领域都凝聚了人类的生活智慧和审美趣味。如世界各国的历史文化和各民族的传统工艺,诸如手工印染、刺绣、编织、绗缝等,无不蕴藏着各式各样的美。


创意灵感来源于一张早年出版的古旧发黄的地图。制作时先按地图的色彩把白色的麻质面料染色,然后剪出需要的形状再烧边,最后用钉上黑色小珠子的红色细绳,模仿标注海拔的地图效果。


灵感来源于中国古代陶瓷的窑变纹样。作者在底层用棉和纱染色,上面钉上裁剪和粘合成放射状花型的色纱,再散布大小珠子。面料的色调和材质巧妙的搭配,模仿陶瓷的纹样。
图文来源于馆藏书籍《服装创意面料设计》和网络
推荐书目

《服装创意面料设计》
作者:杨颐 著
出版社:东华大学出版社
出版时间:2020年8月
索书号:TS941.41/4977
馆藏地:杨浦区图书馆总馆
线上展览

_ | 第一期
I.不会玩面料的设计师不是好匠人 |
第二期 II.时装界男神天团来袭 | _ |
_ | 第三期
III.能长出蕾丝的植物你见过吗? |
第四期 IV.闹洞大开!面料还能这么玩儿? | _ |
_ | 第五期
Ⅴ.天马行空的创意作品,你pick谁? |
编辑:张天一
资料:杨浦文旅
*转载请注明来自上海杨浦官方微信
